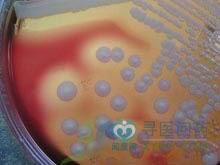

肺炎链球菌脑膜炎在婴儿期较多见,新生儿也可发病。肺炎链球菌脑膜炎其发病率仅次于流行性脑脊髓膜炎,常继发上呼吸道感染、中耳炎、肺炎、鼻窦炎、乳突炎、败血症和颅脑外伤。在儿童脾切除术后、先天性免疫功能缺陷、长期应用免疫抑制剂等情况下,肺炎链球菌脑膜炎可多次发作。
就诊科室:儿科 儿科综合易感人群:婴幼儿需做检查:脑脊液检查-化学检查-蛋白质检查 脑脊液病原体检查(CSF) 脑脊液细菌培养 脑脊液一般性状检查 聚合酶链反应技术 血常规 胸部平片 胸部MRI 胸部CT检查 胸部B超 颅脑CT检查常用药物:注射用青霉素钾 注射用头孢匹胺 注射用氨苄西林钠 甲硝唑胶囊 注射用甲硝唑磷酸二钠 注射用头孢呋辛钠 安宫牛黄丸 注射用苯唑西林钠 头孢羟氨苄甲氧苄啶胶囊 注射用青霉素钠 注射用氨苄西林钠氯唑西林钠 硫酸奈替米星注射液 伊曲康唑分散片 甘油氯化钠注射液 注射用头孢哌酮钠舒巴坦钠 注射用盐酸头孢吡肟 注射用甲磺酸培氟沙星 注射用美洛西林钠舒巴坦钠 注射用阿洛西林钠 脑蛋白水解物注射液 阿莫西林舒巴坦匹酯片典型症状:昏迷 脊柱裂 继发感染 惊厥 颅骨骨折 脑积水 脑膜刺激征 脑膜炎 脑脓肿 细菌感染 细菌性心内膜炎传染方式:无传染性治疗方式:无传染性相关疾病:小儿脑积水 小儿脑脓肿 小儿脑瘫 小儿脑震荡 小儿肺炎 昏迷 头痛 脑膜炎 流行性脑脊髓膜炎 肺炎链球菌脑膜炎在婴儿期较多见,新生儿也可发病。肺炎链球菌脑膜炎其发病率仅次于流行性脑脊髓膜炎,常继发上呼吸道感染、中耳炎、肺炎、鼻窦炎、乳突炎、败血症和颅脑外伤。在儿童脾切除术后、先天性免疫功能缺陷、长期应用免疫抑制剂等情况下,肺炎链球菌脑膜炎可多次发作。
肺炎链球菌脑膜炎在婴儿期较多见,新生儿也可发病。肺炎链球菌脑膜炎其发病率仅次于流行性脑脊髓膜炎,常继发上呼吸道感染、中耳炎、肺炎、鼻窦炎、乳突炎、败血症和颅脑外伤。在儿童脾切除术后、先天性免疫功能缺陷、长期应用免疫抑制剂等情况下,肺炎链球菌脑膜炎可多次发作。